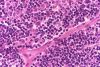

|

Lymph node - histology slide
|
|

Lymph node - histology slide
|
|
Lymph node - histology slide
|
|

Lymph node - histology slide
|
|

Lymph node - histology slide
|
|

Lymph node - histology slide
|
|

Lymph node - histology slide
|
|

Lymph node - histology slide
|
|

Lymph node - histology slide
|
|

Lymph node - histology slide
|
|

Lymph node - histology slide
|
|

Lymph node - histology slide
|
|
50 files on 5 page(s) |
2 |  |
 |
|